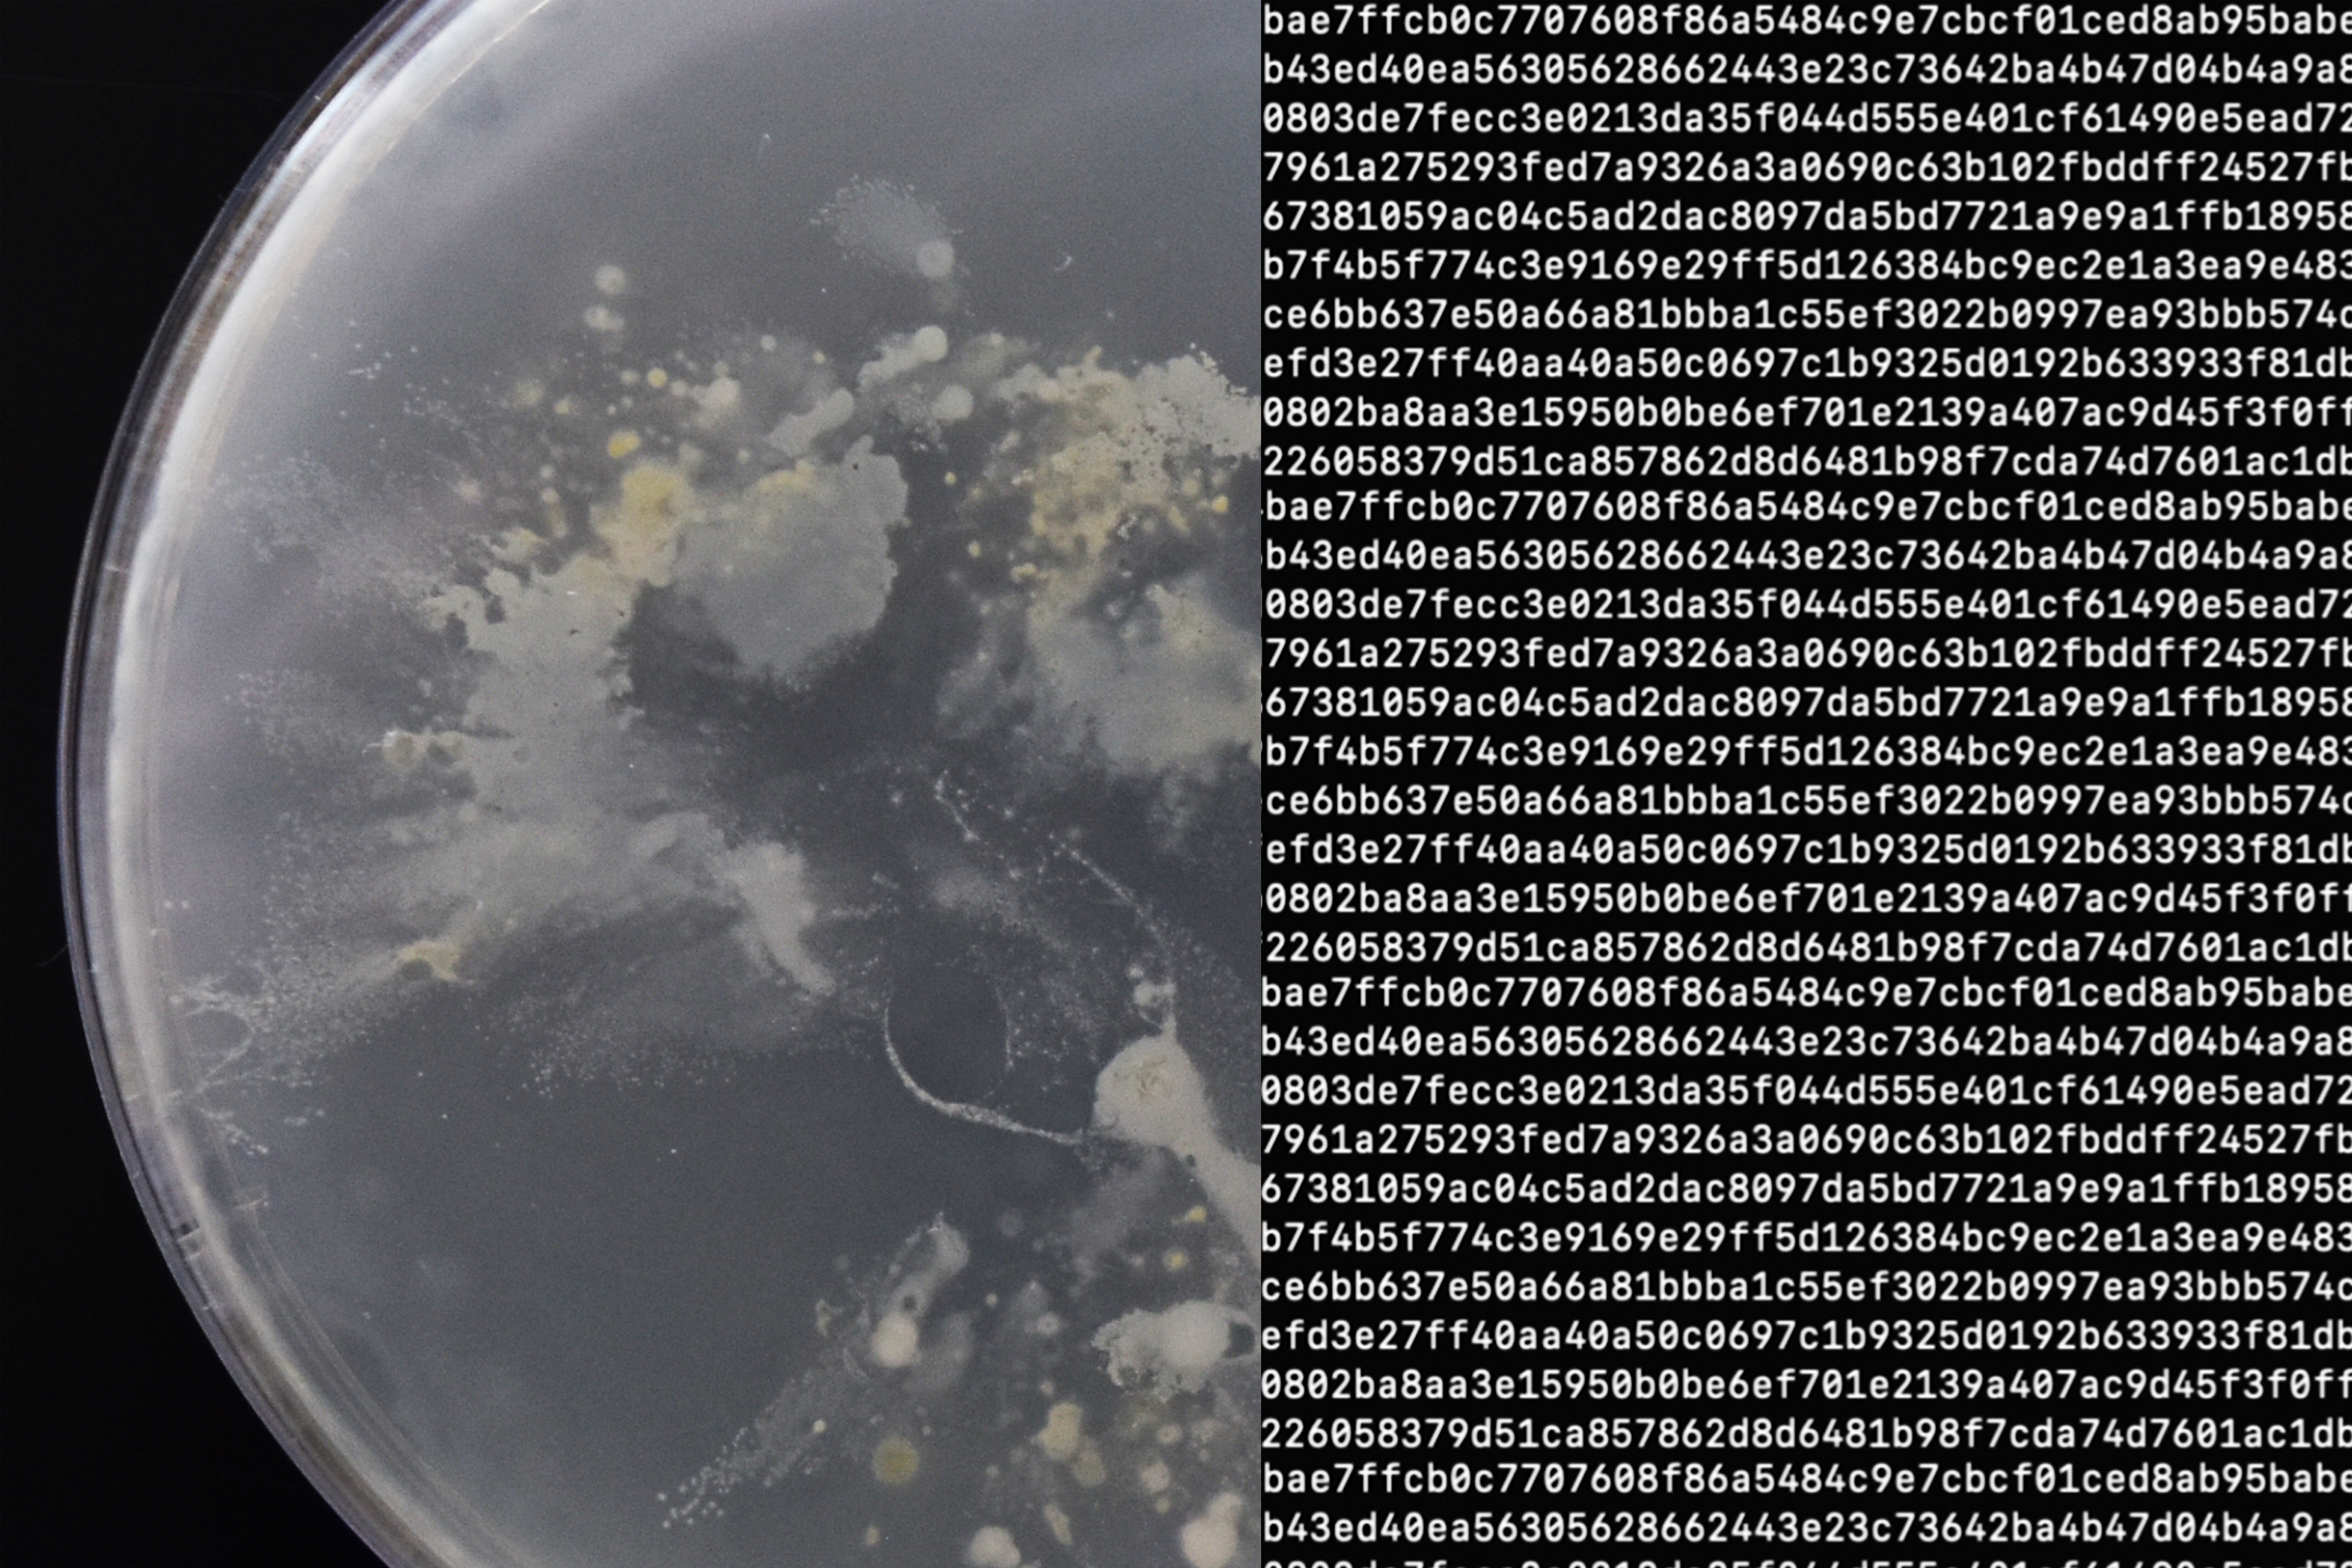

Presented here is a two part project. Firstly, a proof of concept for Bacteria as a Digital Mediator Random Number Generator, which resulted from collaboration with software programmers and Open Cell. And secondly, a proposal for an interactive installation that brings to life the worlds of microbiology and cryptography and invites the audience to play with these apparently abstract but critical topics.
Bacteria as a Digital Mediator
RCA2020, Royal College of Art
2020
In collaboration with Open Cell, Erik Lintunen and Phillip Quiza
RCA2020, Royal College of Art
2020
In collaboration with Open Cell, Erik Lintunen and Phillip Quiza
Every time you establish a secure web connection your device and the computer it’s communicating with exchange a pair of numbers. These are used to create a temporary encryption key. The described process is a cryptography technique that relies on a chain of random numbers in order to keep your information safe.
There are two types of random numbers: true and pseudo. Unless it is by chance, a true random number is a sequence of numbers or symbols that cannot be predicted. Pseudo-random number behaviour, on the other hand, can be predicted if the generation method is known.
To ensure the safety of online communications we need true random numbers. Such sequences can be found when a machine works with physical phenomena.
There are two types of random numbers: true and pseudo. Unless it is by chance, a true random number is a sequence of numbers or symbols that cannot be predicted. Pseudo-random number behaviour, on the other hand, can be predicted if the generation method is known.
To ensure the safety of online communications we need true random numbers. Such sequences can be found when a machine works with physical phenomena.
Currently there are some true random number generators (RNGs) which use white noise, radioactive decay or even lava lamps as their source.
With 4.57 billion of us actively using the internet and the growing threat of cyber security, further exploration is needed of new and reliable sources of entropy for true random number generators.
Presented here is a two part project. Firstly, a proof of concept for Bacteria as a Digital Mediator RNG, which resulted from collaboration with software programmers and Open Cell. And secondly, a proposal for an interactive installation that brings to live the worlds of microbiology and cryptography and invites the audience to play with these apparently abstract but critical topics.
With 4.57 billion of us actively using the internet and the growing threat of cyber security, further exploration is needed of new and reliable sources of entropy for true random number generators.
Presented here is a two part project. Firstly, a proof of concept for Bacteria as a Digital Mediator RNG, which resulted from collaboration with software programmers and Open Cell. And secondly, a proposal for an interactive installation that brings to live the worlds of microbiology and cryptography and invites the audience to play with these apparently abstract but critical topics.


As a designer, I was interested in the singularity of a human hand and it became apparent that a source of true randomness lies literally at our fingertips. Building on the knowledge that everyone has a unique and fluctuating hand microbiome a method has been designed to carry out hashing functions (where the input becomes a seed for a random number) from the process of cultivating bacteria colonies. These initial tests demonstrate the untapped potential of human hand bacteria to generate true random numbers.
To start a conversation and take the project further, the proposed installation would invite the audience to engage with this topic. Through the interaction, human hand bacteria can be collected in order to further the research. Both as a speculative provocation in an education and cultural context, Bacteria as a Digital Mediator RNG could have applications in technology, science and art industry.
Below is a close up view of the capsule design that also holds the petri dish and an overview of the relationship between the installation and the random number generator.
Below is a close up view of the capsule design that also holds the petri dish and an overview of the relationship between the installation and the random number generator.



